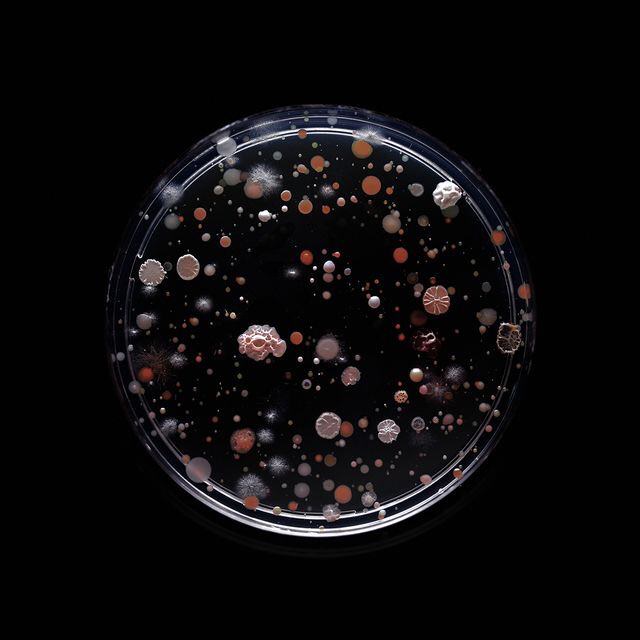

キノコ・海藻・細菌・ウイルス・ぶつぶつ恐怖症のやついたらちょっと来い
1: 風吹けば名無し 2018/03/25(日) 14:50:25.92 ID:ogLU85uq0
おんJ怖い話だいすこ部
http://blog.livedoor.jp/nwknews/archives/5343463.html
こいつら、たまらなくキモいんじゃーーー~
この気持ち、わかる奴おるか??
キノコ(菌類、Fungi)
非植物。葉緑体を持たず、光合成も行わない従属栄養生物。体が多数の菌糸から構成されている糸状菌のうち、単細胞のままで繁殖するものは酵母と呼ばれる。




海藻(藻類、algae)
はじめて光合成を行った動物・シアノバクテリアに端を発する原始植物。シアノバクテリア(のちの葉緑体)を取り込んだ生物は「植物」と呼称されることになった。



細菌(vacteria)
極小の単細胞生物群。他物に寄生して発酵や腐敗を起こし、また病原となるものもある。分裂菌。バクテリア。


ウイルス(virus)
非生物。物質と生命の中間。結晶化する。生物ではないので代謝機能がない。生物細胞に寄生し、その代謝機能を利用して繁殖する。


続きを読む

-
画像